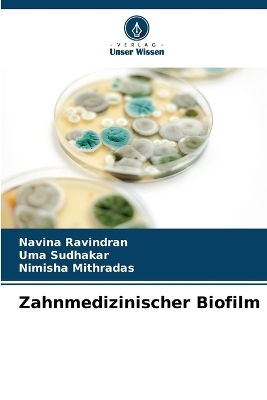
Zahnmedizinischer Biofilm - Navina Ravindran, Uma Sudhakar, Nimisha Mithradas

Zahnmedizinischer Biofilm
Seiten
2023
Verlag Unser Wissen
978-620-6-66109-2 (ISBN)
Verlag Unser Wissen
978-620-6-66109-2 (ISBN)
- Keine Verlagsinformationen verfügbar
- Artikel merken
Mikrobielle Biofilme sind in der Natur weit verbreitet. Praktisch jede flüssige Umgebung, in der Mikroorganismen Stress oder Strömung ausgesetzt sind, kann Bedingungen für das Wachstum von Biofilmen schaffen. Der Mund ist eine ideale Umgebung für die Entwicklung von Biofilmen. Entdeckungen auf dem Gebiet der klinischen Mikrobiologie gab es von den späten 1800er bis zu den frühen 1900er Jahren. Von Mitte der 1960er bis in die 1970er Jahre wurde die Beschaffenheit von Zahnbelag zu einem wichtigen Thema für Zahnwissenschaftler und die zahnmedizinische Forschungsgemeinschaft. Das folgende Buch zum Thema "Biofilm" bietet einen Einblick in die orale Mikroflora, den Zahnbelag, der den Biofilm darstellt, seine Struktur, Zusammensetzung, Wachstumsdynamik, Eigenschaften, das Prinzip der Übertragung, die Verbindung von Plaque-Mikroorganismen mit Parodontalerkrankungen, seine Auswirkungen auf die systemische Gesundheit und seine Präventionsstrategien mit zukünftigen Fortschritten in der parodontalen Mikrobiologie.
Dr. Navina Ravindran, Assistenzprofessorin, Abteilung für Parodontologie, Thai Moogambigai Dental College.Dr. Uma Sudhakar, Professorin & HOD, Abteilung für Parodontologie, Thai Moogambigai Dental College.Dr. Nimisha Mithradas, Außerordentliche Professorin, Abteilung für Parodontologie, Thai Moogambigai Dental College.
| Erscheinungsdatum | 15.11.2023 |
|---|---|
| Sprache | deutsch |
| Maße | 152 x 229 mm |
| Gewicht | 154 g |
| Themenwelt | Medizin / Pharmazie ► Zahnmedizin |
| Schlagworte | Porphyromonas gingivalis • Zahnbelag |
| ISBN-10 | 620-6-66109-1 / 6206661091 |
| ISBN-13 | 978-620-6-66109-2 / 9786206661092 |
| Zustand | Neuware |
| Informationen gemäß Produktsicherheitsverordnung (GPSR) | |
| Haben Sie eine Frage zum Produkt? |
Mehr entdecken
aus dem Bereich
aus dem Bereich
Tiergestützte Therapie in der Zahnmedizin | Orale Medizin Band 2
Buch | Softcover (2025)
Lehmanns Media (Verlag)
CHF 27,90
Zahntechnische Leistungen sicher erkennen, vollständig dokumentieren, …
Buch | Spiralbindung (2025)
Spitta GmbH (Verlag)
CHF 268,10


